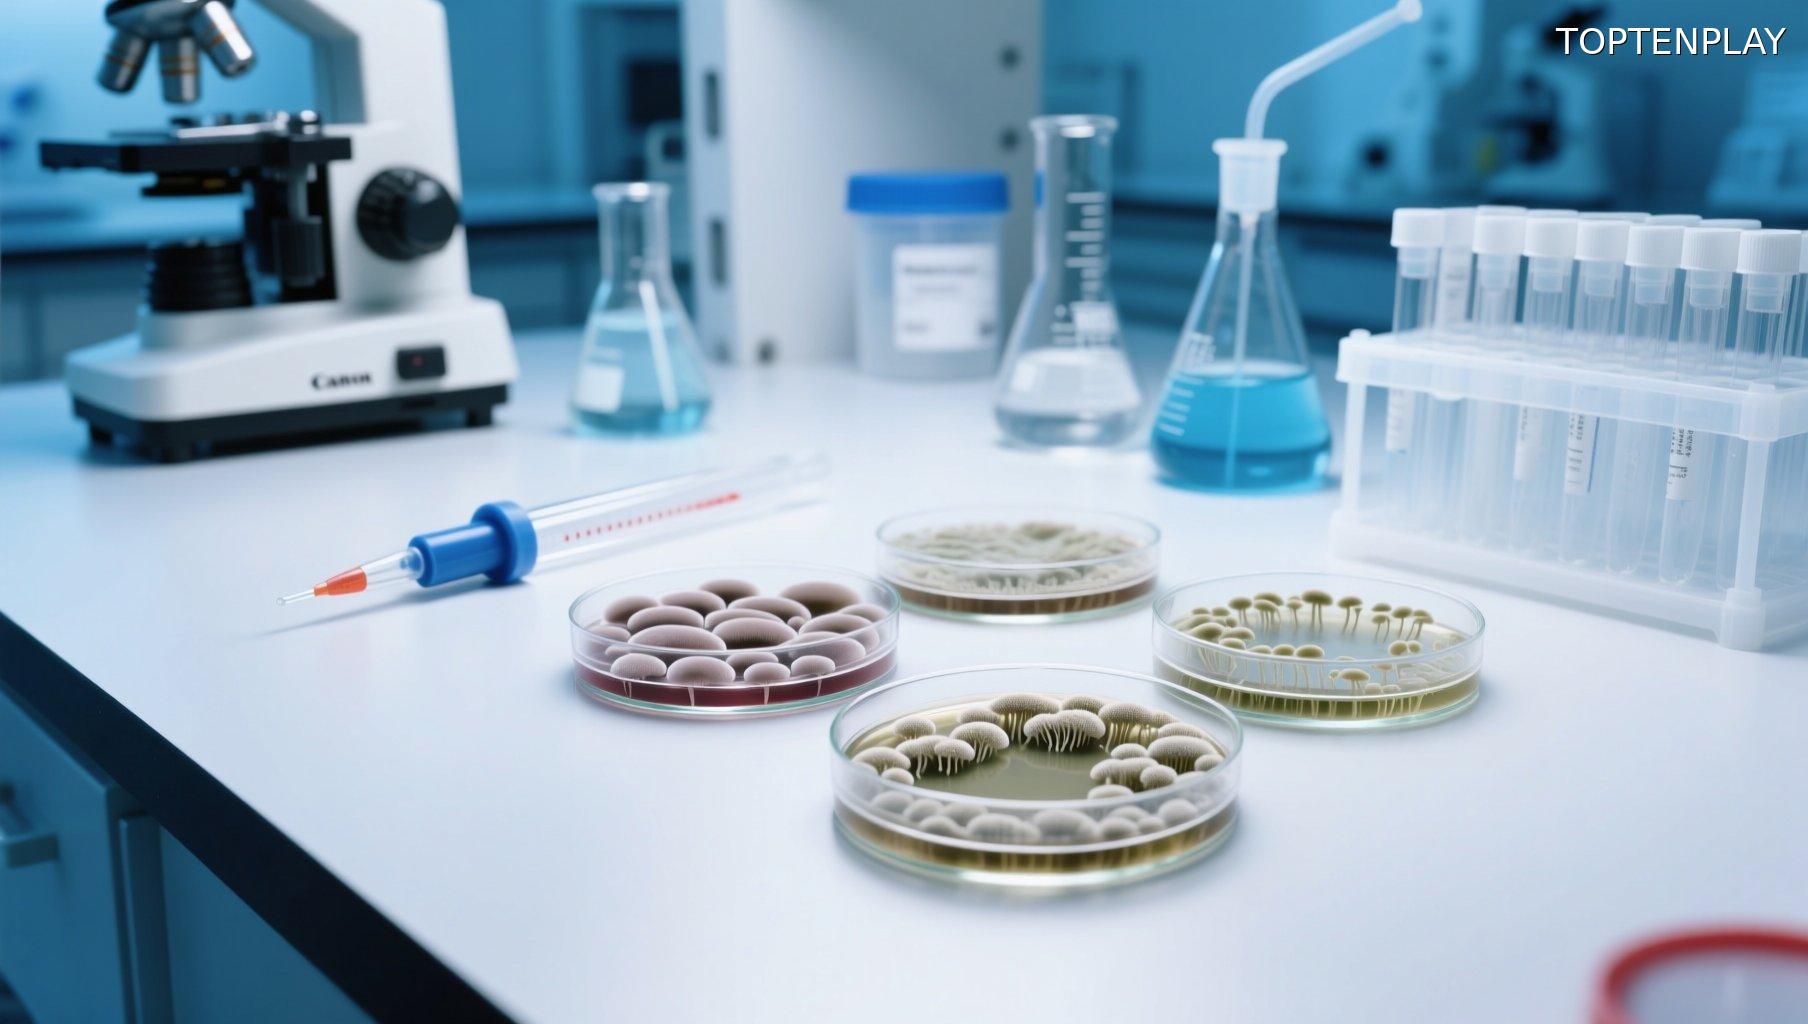
Image d'illustration © TopTenPlay

📌 Le champignon de la « malédiction des pharaons » pourrait révolutionner la lutte contre la leucémie
Posted 23 septembre 2025 by: Admin

De La Malédiction Antique À L’Espoir Médical
Dans les profondeurs des tombeaux de Toutânkhamon, un tueur silencieux attendait depuis des millénaires. L’Aspergillus flavus, ce champignon redoutable, avait déjà fait ses preuves en provoquant la mort des premiers archéologues qui osèrent profaner les sépultures royales. Causant des infections pulmonaires sévères, ce micro-organisme alimentait les légendes de malédictions pharaoniques qui frappaient quiconque perturbait le repos éternel des souverains.
Pourtant, près d’un siècle après ces tragédies, ce même agent pathogène pourrait bien devenir un allié inattendu dans la lutte contre le cancer. Une étude révolutionnaire publiée dans la prestigieuse revue Nature Chemical Biology vient bouleverser notre perception de cet ancien fléau. Les chercheurs ont réussi l’exploit de transformer ce champignon mortel en une source prometteuse de traitements anticancéreux.
Cette découverte illustre parfaitement l’ironie de la science moderne : ce qui jadis semait la mort dans les couloirs poussiéreux des pyramides pourrait bientôt sauver des milliers de vies dans les hôpitaux du monde entier. L’Aspergillus flavus s’apprête ainsi à passer du statut de gardien maudit des tombes à celui de gardien de l’espoir médical, ouvrant des perspectives thérapeutiques totalement inédites.
Les Aspérigymycines : Une Arme Moléculaire Contre La Leucémie
Cette transformation remarquable repose sur une découverte moléculaire d’une précision chirurgicale. Les scientifiques ont isolé des peptides RiPPs – acronyme pour les peptides synthétisés par ribosome et modifiés post-traductionnellement – contenus dans l’Aspergillus flavus. Après purification, ces composés ont révélé leur véritable trésor : des molécules à la structure complexe d’anneaux imbriqués, baptisées « aspérigymycines ».
Deux de ces aspérigymycines ont démontré un potentiel thérapeutique saisissant lors des tests sur cellules cancéreuses humaines. Leur cible de prédilection ? Les cellules leucémiques, contre lesquelles elles déploient une efficacité remarquable. Plus surprenant encore, l’une d’entre elles, enrichie d’une molécule présente dans la gelée royale – cet actif précieux de la ruche – a égalé les performances de deux piliers du traitement anticancéreux : la cytarabine et la daunorubicine, utilisées depuis des décennies.
Cette équivalence thérapeutique avec les médicaments de référence constitue un tournant majeur. Les aspérigymycines ne se contentent pas d’exister, elles rivalisent directement avec les traitements établis, ouvrant la voie à des alternatives thérapeutiques potentiellement moins toxiques. Mais comment ces molécules parviennent-elles à pénétrer si efficacement dans leurs cibles cancéreuses ?

Un Mécanisme D’Infiltration Révolutionnaire
La réponse réside dans une stratégie d’infiltration d’une sophistication inouïe. Les aspérigymycines exploitent le gène SLC46A3, présent spécifiquement dans les cellules leucémiques, pour forcer leur entrée dans ces forteresses cancéreuses. « Ce gène agit comme une passerelle », explique le Dr Qiuyue Nie, auteur principal de l’étude. « Il permet non seulement aux aspérigimycines de pénétrer dans les cellules, mais pourrait également permettre à d’autres peptides cycliques d’en faire autant. »
Cette découverte révèle un mécanisme de ciblage thérapeutique d’une précision chirurgicale. Contrairement aux chimiothérapies conventionnelles qui frappent aveuglément, les aspérigymycines font preuve d’une sélectivité remarquable. Les tests démontrent leur totale inefficacité contre les cellules cancéreuses du sein, du foie ou du poumon, ainsi que sur diverses bactéries et champignons.
Cette spécificité d’action, loin d’être une limitation, constitue exactement ce que recherchent les oncologues. Elle préfigure une nouvelle génération de traitements capables de distinguer leurs véritables cibles des cellules saines, réduisant drastiquement les effets secondaires dévastateurs de la chimiothérapie traditionnelle.
Le gène SLC46A3 pourrait ainsi devenir la clé d’une révolution thérapeutique, ouvrant la voie à toute une famille de peptides cycliques conçus pour exploiter cette même porte d’entrée moléculaire.

Vers Une Nouvelle Ère De La Pharmacie Naturelle
Cette révolution thérapeutique ne se limite pas à l’Aspergillus flavus. L’équipe de chercheurs a identifié des RiPPs aux propriétés thérapeutiques similaires dans d’autres espèces fongiques, révélant un trésor pharmaceutique encore largement inexploité. « Même si seuls quelques-uns ont été découverts, presque tous présentent une forte bioactivité », confie le Dr Nie. « Il s’agit d’un domaine inexploré au potentiel énorme. »
Cette découverte redéfinit notre approche du développement médicamenteux. Pendant des décennies, l’industrie pharmaceutique s’est concentrée sur la synthèse chimique, négligeant les ressources naturelles qui recèlent pourtant des solutions d’une complexité inégalée.
Les aspérigymycines franchissent désormais une étape cruciale : les tests sur modèles animaux débuteront prochainement, préparant la voie aux essais cliniques humains. Cette progression méthodique pourrait transformer un champignon autrefois mortel en thérapie révolutionnaire contre la leucémie.
« La nature nous a offert cette incroyable pharmacie. À nous d’en percer les secrets », déclare le Dr Xue Gao, professeur associé du Presidential Penn Compact. « En tant qu’ingénieurs, nous sommes impatients de poursuivre nos explorations, d’apprendre de la nature et d’utiliser ces connaissances pour concevoir de meilleures solutions. »
Cette vision transforme radicalement notre relation aux organismes pathogènes, révélant que nos plus anciens ennemis pourraient détenir les clés de notre guérison.










